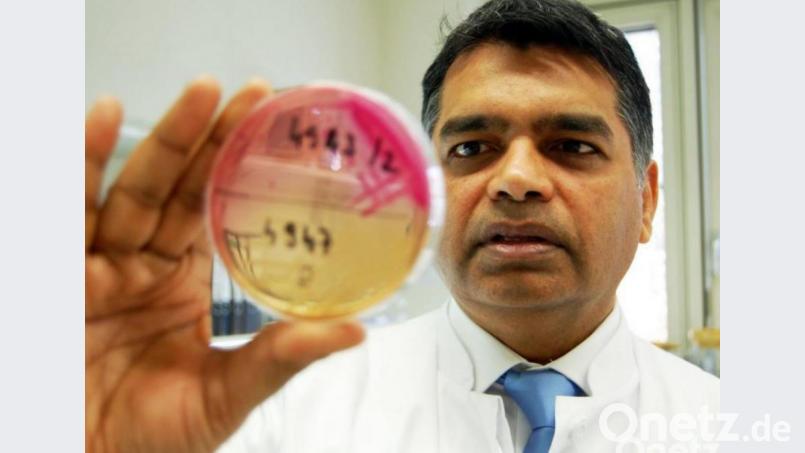

St. Marien sei räumlich, technisch und auch personell "sehr gut vorbereitet". Das Krankenhaus verfüge über mehrere Betten auf der Infektionsstation, die räumlichen Ressourcen und Abläufe würden außerdem laufend den Gegebenheiten angepasst.
Hossain sagt aber auch ganz deutlich: "Um eine Ausbreitung des Coronavirus zu verhindern, sind wir aber auch auf die Unterstützung der Bevölkerung angewiesen." Konkret heißt das: Krankenbesuche sollten auf ein Minimum reduziert werden, denn: "Jeder Besuch birgt das Risiko, Infektionserreger von außen ins Krankenhaus zu tragen." Das Motto lautet: "So wenig Besuche wie möglich und so viel wie nötig." Zudem sollten beim Betreten des Hauses und der Zimmer die Hände immer desinfiziert werden. Auf das Händeschütteln sollte zudem grundsätzlich verzichtet werden.
Besteht ein Verdacht auf eine Infektion mit dem Coronavirus, soll in Anlehnung an die Empfehlungen des Robert-Koch-Instituts das zuständige Gesundheitsamt kontaktiert werden, um das weitere Vorgehen abzustimmen. Bei einem Verdacht empfiehlt auch Hossain, den Hausarzt oder die Kassenärztliche Vereinigung (Telefon 11 61 17) anzurufen. Nur Patienten mit schwereren Symptomen, die voraussichtlich stationär behandelt werden müssen, sollten die Notaufnahme des Klinikums aufsuchen, sich dort aber zwingend vorher anmelden. Möglich ist das unter 38-13 39.
Außerdem sollte möglichst keine Begleitperson mitkommen. Nur zur reinen Entnahme eines Rachenabstrichs sollte die Notaufnahme nicht aufgesucht werden. Es herrsche große Verunsicherung, sagt Hossain, aber: "Unnötige Panik bringt uns auch nicht weiter. Was wir aber tun können, ist ein achtsamer Umgang - zum Vorteil für uns selbst und unsere Angehörigen."

Um Kommentare verfassen zu können, müssen Sie sich anmelden.
Bitte beachten Sie unsere Nutzungsregeln.